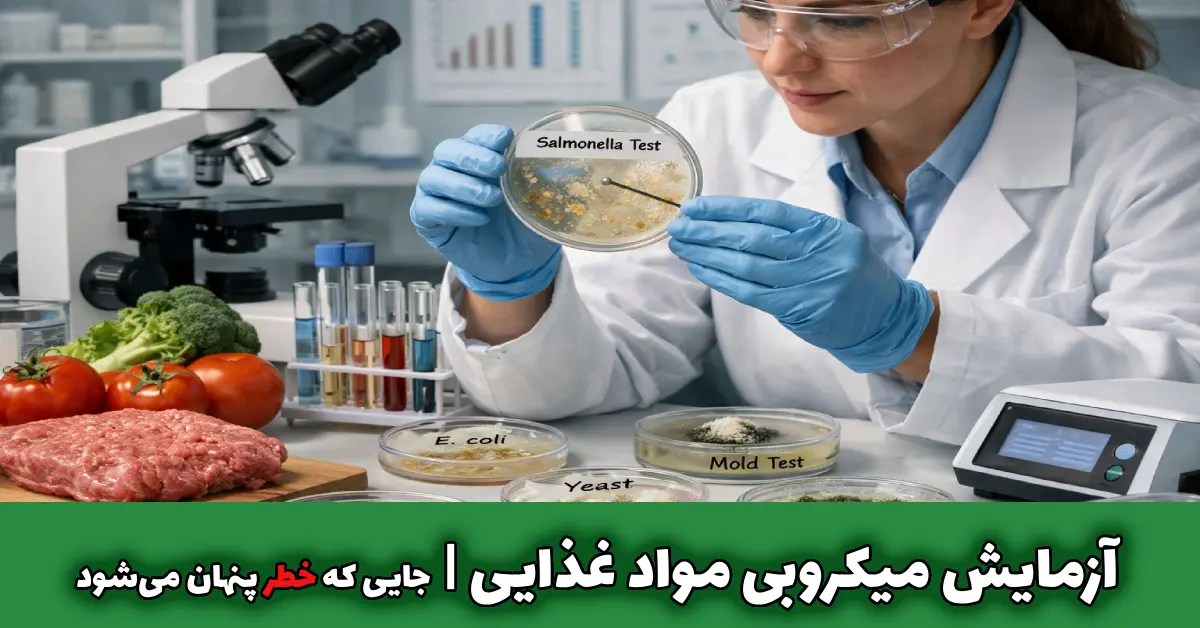
آزمایش میکروبی مواد غذایی جایی که خطر پنهان میشود

آزمایش میکروبی مواد غذایی | چه چیزی واقعاً سلامت غذا را تهدید میکند؟
آیا میتوان تنها با ظاهر، بو یا طعم، درباره سلامت یک ماده غذایی قضاوت کرد؟
پاسخ روشن است: خیر. بخش اصلی خطرات غذایی در جایی پنهان میشود که با حواس انسانی قابل تشخیص نیست. آزمایش میکروبی مواد غذایی دقیقاً برای شناسایی همین لایه پنهان طراحی شده است؛ جایی که تصمیمها باید بر پایه داده علمی گرفته شوند، نه حدس.
با این حال، انجام آزمایش بهتنهایی کافی نیست. آنچه اهمیت دارد، درک درست نتایج، محدودیتها و پیامدهای این آزمونهاست. بدون این شناخت، عددها فقط عدد باقی میمانند و نقش واقعی خود را در ایمنی غذایی از دست میدهند.
در ادامه، بهجای توضیحهای کلی، وارد منطق و سازوکار این آزمایشها میشویم؛ از جایی که علم، بهصورت عملی وارد حفاظت از سلامت مصرفکننده میشود.
آزمایش میکروبی مواد غذایی دقیقاً چیست؟
در سادهترین تعریف، آزمایش میکروبی مواد غذایی مجموعهای از آزمونهای آزمایشگاهی استاندارد است که برای شناسایی، اندازهگیری و تحلیل میکروارگانیسمها در مواد غذایی انجام میشود. این آزمونها بهدنبال چیزی هستند که با حواس انسانی قابل تشخیص نیست، اما نقش مستقیمی در ایمنی و سلامت دارد.
میکروارگانیسمهایی که در این آزمایشها بررسی میشوند، معمولاً در چهار گروه اصلی قرار میگیرند:
- باکتریها که میتوانند شاخص بهداشت یا عامل بیماری باشند
- مخمرها که اغلب با فساد و تغییر کیفیت مرتبطاند
- کپکها که برخی از آنها توان تولید سموم خطرناک دارند
- عوامل بیماریزا که حتی در مقادیر بسیار کم نیز ریسک ایجاد میکنند
هدف این آزمایشها صرفاً یافتن آلودگی نیست، بلکه تشخیص آلودگیهایی است که:
- با چشم دیده نمیشوند
- با بو یا طعم قابل تشخیص نیستند
- اما میتوانند مستقیماً ایمنی غذایی را تحت تأثیر قرار دهند
به همین دلیل، این آزمایشها مبنای تصمیمگیری علمی درباره سلامت یک ماده غذایی محسوب میشوند، نه یک بررسی ظاهری یا حدسی.

چرا آزمایش میکروبی مواد غذایی حیاتی است؟
پیچیدگی تولید و زنجیره تأمین مواد غذایی باعث میشود حتی کوچکترین خطاها، پیامدهای جدی به همراه داشته باشند. آزمایش میکروبی مواد غذایی نه یک کار تشریفاتی، بلکه یک ابزار حیاتی برای حفاظت از سلامت مصرفکننده است.
دلایل اهمیت این آزمایشها به طور اصلی عبارتند از:
- پیشگیری از مسمومیت غذایی: شناسایی میکروبهای بیماریزا قبل از رسیدن به مصرفکننده
- کاهش ریسک شیوع بیماریهای میکروبی: کنترل و حذف عوامل بالقوه خطرناک در مراحل اولیه
- اطمینان از انطباق با استانداردهای بینالمللی: تضمین پذیرش محصولات در بازارهای داخلی و خارجی
- افزایش ماندگاری واقعی محصول: تشخیص عوامل فسادزای میکروبی و مدیریت عمر مفید
- کنترل کیفیت در زنجیره تولید: مشاهده و اصلاح نقاط حساس از تولید تا بستهبندی
نکته کلیدی اینجاست که بسیاری از آلودگیهای میکروبی در مراحل اولیه تولید شکل میگیرند، اما اثر واقعی آنها معمولاً در زمان مصرف نهایی ظاهر میشود.
آلودگی میکروبی مواد غذایی چگونه ایجاد میشود؟
آلودگی میکروبی معمولاً نتیجه ترکیب چند عامل همزمان است، نه یک اشتباه واحد. جدول زیر مهمترین عوامل و نحوه تأثیر آنها را نشان میدهد:
| عامل | توضیح کوتاه | نمونه / نکته |
|---|---|---|
| مواد اولیه آلوده | مواد خام میتوانند حامل میکروارگانیسمهای بیماریزا باشند | محصولات دامی، سبزیجات خام، آب مصرفی در فرآیند تولید |
| شرایط نامناسب فرآوری | دما، رطوبت و زمان هرگونه انحراف از استاندارد رشد میکروبها را فعال میکند | نگهداری نادرست، پخت ناقص، محیط تولید نامناسب |
| آلودگی متقاطع | تماس محصول سالم با تجهیزات، دست کارکنان یا سطوح آلوده | لمس تجهیزات آلوده یا ظروف ذخیرهسازی غیربهداشتی |
| بستهبندی غیراستاندارد | ورود اکسیژن، رطوبت یا آلودگی محیطی باعث تسریع رشد میکروبها میشود | بستهبندی آسیبدیده یا نفوذپذیر به رطوبت و هوا |
💡 این عوامل بهصورت ترکیبی میتوانند باعث ایجاد آلودگی میکروبی مواد غذایی شوند، حتی اگر هر عامل بهتنهایی کوچک و قابل کنترل به نظر برسد.
چه میکروارگانیسمهایی در آزمایش میکروبی بررسی میشوند؟
در آزمایش میکروبی مواد غذایی تمرکز تنها بر «وجود یا عدم وجود» نیست؛ بلکه نوع، تعداد و نقش هر میکروارگانیسم اهمیت دارد.
جدول زیر مهمترین گروهها و اثرات آنها را نشان میدهد:
| گروه میکروارگانیسم | نقش و اهمیت | نمونه / نکته |
|---|---|---|
| باکتریهای شاخص | نشانگر بهداشت فرآیند و کیفیت کلی محصول | باکتریهای هوازی مزوفیل، کلیفرمها، انتروباکتریاسهها |
| باکتریهای بیماریزا | حتی مقادیر کم میتوانند ریسک جدی ایجاد کنند | سالمونلا، لیستریا مونوسیتوژنز، اشریشیا کلی O157:H7 |
| مخمرها و کپکها | بیشتر با فساد و کاهش کیفیت محصول مرتبطاند؛ برخی کپکها تولید سموم قارچی میکنند | تغییر طعم و بو، کاهش ماندگاری، تولید توکسینهای قارچی |
💡 این بررسیها به تولیدکننده و مصرفکننده امکان میدهد درک علمی و عملی از سلامت و ایمنی محصول داشته باشند و تصمیمهای دقیق بر اساس دادهها گرفته شود.

آزمایش میکروبی مواد غذایی چه اطلاعاتی به ما میدهد؟
نتایج آزمایش میکروبی مواد غذایی صرفاً یک عدد یا گزارش خشک نیستند؛ این دادهها در واقع ابزار تصمیمگیری علمی برای تولیدکننده و کنترلکننده کیفیت هستند.
با تحلیل صحیح، میتوان سلامت محصول و ایمنی مصرفکننده را تضمین کرد و از تصمیمهای حدسی جلوگیری نمود.
اطلاعات کلیدی که از این آزمایشها به دست میآید، شامل موارد زیر است:
- وضعیت واقعی بهداشت محصول: درک دقیق میزان آلودگی و سلامت میکروبی هر دسته محصول
- کارایی فرآیند تولید: سنجش اثر بخشی روشهای بهداشتی و فرآوری در کاهش میکروبها
- میزان ریسک مصرف: تعیین سطح ایمنی برای مصرفکننده و شناسایی نقاط حساس
- قابلیت عرضه در بازارهای مختلف: اطمینان از انطباق با استانداردهای داخلی و بینالمللی
- نیاز یا عدم نیاز به اصلاح فرآیند: تصمیمگیری علمی برای بهبود تولید و جلوگیری از خطاهای آینده
تحلیل درست این دادهها مرز بین کنترل علمی کیفیت و حدس و گمان است؛ یعنی همان نقطهای که آزمایش میکروبی مواد غذایی واقعاً معنا پیدا میکند و ارزش عملی خود را نشان میدهد.
تفاوت شمارش میکروبی و شناسایی پاتوژنها
در آزمایش میکروبی مواد غذایی، دو روش اصلی اغلب با هم اشتباه گرفته میشوند: شمارش میکروبی و شناسایی پاتوژنها. هر کدام هدف و کاربرد مشخصی دارند و درک درست این تفاوت برای تحلیل نتایج حیاتی است.
- شمارش میکروبی:
این روش سطح کلی آلودگی محصول را اندازهگیری میکند و نتایج آن به صورت عددی (CFU/g یا CFU/ml) گزارش میشود. هدف، ارزیابی وضعیت بهداشت عمومی و کیفیت تولید است. - شناسایی پاتوژنها:
این آزمون برای تشخیص وجود یا عدم وجود میکروارگانیسمهای بیماریزا طراحی شده است. حتی یک واحد پاتوژن میتواند خطر بالقوهای برای مصرفکننده ایجاد کند، بنابراین تمرکز این روش روی ریسک واقعی سلامت است.
آیا همه مواد غذایی به آزمایش میکروبی نیاز دارند؟
تقریباً همه مواد غذایی نیازمند ارزیابی میکروبی هستند، اما سطح و نوع آزمایش بسته به ویژگیهای محصول متفاوت است.
عوامل تعیینکننده نیاز به آزمایش شامل موارد زیر هستند:
- ماهیت ماده غذایی:
محصولات حیوانی، خام یا فرآورینشده حساسیت بیشتری دارند و نیازمند بررسی دقیقتر هستند. - میزان رطوبت:
رطوبت بالا محیط رشد میکروبها را تسهیل میکند و میتواند خطر آلودگی را افزایش دهد. - pH محصول:
محیطهای اسیدی یا قلیایی رشد برخی میکروبها را محدود میکنند، اما کنترل میکروبی هنوز ضروری است. - روش نگهداری:
دما و شرایط بستهبندی نقش تعیینکنندهای در ایمنی محصول دارند. - جمعیت مصرفکننده:
محصولاتی که برای کودکان، سالمندان یا افراد با سیستم ایمنی ضعیف تولید میشوند، نیازمند کنترل میکروبی دقیقتر هستند.
اگر میخواهید بدانید کدام مواد غذایی نیازمند بررسی میکروبی هستند و چند تست کلیدی برای سنجش سلامت غذا چیست، مقاله آیا غذای شما واقعا سالم است را بخوانید.

روشهای استاندارد آزمایش میکروبی مواد غذایی
آزمایش میکروبی مواد غذایی یک روش واحد نیست؛ بلکه مجموعهای از روشهای استاندارد و تأییدشده بینالمللی وجود دارد که بسته به نوع ماده غذایی و هدف آزمون انتخاب میشوند. انتخاب روش نادرست میتواند تصویر نهایی از سلامت محصول را کاملاً گمراه کند.
1. روش کشت کلاسیک
این روش را میتوان ستون فقرات آزمایش میکروبی مواد غذایی دانست، چرا که پایه اکثر تحلیلها و تصمیمهای علمی است.
✅ ویژگیهای اصلی این روش:
- مبتنی بر رشد واقعی میکروارگانیسمها است و نتایج ملموس ارائه میدهد
- دقت بالا در شناسایی و شمارش میکروبها
- امکان شمارش دقیق تعداد کلونیها برای تحلیل کمّی
❌ با این حال، محدودیتهایی هم دارد:
- زمانبر بودن فرآیند، گاهی تا چند روز طول میکشد
- نیاز به شرایط کنترلشده دقیق برای رسیدن به نتایج قابل اعتماد
نکته حرفهای: انتخاب این روش مناسب برای اکثر مواد غذایی و آزمونهای استاندارد است، اما ترکیب آن با روشهای سریعتر میتواند تصویری کاملتر از سلامت محصول ارائه دهد.
2. روش شمارش کل میکروبی
روش شمارش کل میکروبی یکی از پایهایترین ابزارها در آزمایش میکروبی مواد غذایی است و برای ارائه تصویر کلی از وضعیت بهداشتی محصول استفاده میشود. این روش تعداد کل میکروارگانیسمهای زنده در نمونه را اندازهگیری میکند و مبنای بسیاری از تصمیمهای علمی در کنترل کیفیت است.
✅ ویژگیهای اصلی این روش:
- مبتنی بر اندازهگیری مستقیم تعداد میکروارگانیسمها
- ارائه تصویر کلی از بهداشت و ایمنی محصول
- امکان ارزیابی کمی دقیق با واحدهای CFU/g یا CFU/ml
❌ با این حال، محدودیتهایی هم دارد:
- ارائه تصویر کلی است و نمیتواند وجود پاتوژن خاص را مشخص کند
- ممکن است زمانبر باشد و نیازمند شرایط کنترلشده دقیق است
نکته حرفهای: این روش برای ارزیابی سطح کلی آلودگی، کنترل فرآیند تولید و سنجش اثربخشی نگهداری بسیار مناسب است، اما برای تشخیص عوامل بیماریزا باید با روشهای شناسایی پاتوژن ترکیب شود.
3. روش شناسایی عوامل بیماریزا
روش شناسایی عوامل بیماریزا یکی از حیاتیترین مراحل آزمایش میکروبی مواد غذایی است. تمرکز این روش فقط بر وجود یا عدم وجود میکروارگانیسمهای بیماریزا است و نقش مستقیم در تضمین ایمنی مصرفکننده دارد.
✅ ویژگیهای اصلی این روش:
- حساسیت بسیار بالا: قادر به شناسایی حتی کمترین مقدار پاتوژن
- الزامات سختگیرانه: رعایت دقیق پروتکلهای استاندارد بینالمللی الزامی است
- عدم تحمل خطا: هر نتیجه مثبت میتواند نشاندهنده ریسک جدی برای مصرفکننده باشد
❌ با این حال، محدودیتهایی هم دارد:
- این روش تعداد میکروبها را نشان نمیدهد و برای تصویر کلی به روش شمارش کل میکروبی نیاز دارد
- نیازمند تجهیزات و شرایط کنترلشده دقیق است
نکته حرفهای: حتی یک نتیجه مثبت در این آزمون میتواند به معنای غیرقابل مصرف بودن محصول باشد، بنابراین ترکیب آن با روشهای دیگر، مانند شمارش کل میکروبی، تصویری کامل از سلامت محصول ارائه میدهد.
4. روشهای سریع
روشهای سریع برای آزمایش میکروبی مواد غذایی توسعه یافتهاند تا زمان پاسخ و تصمیمگیری کاهش یابد و امکان پایش سریعتر فرآیند تولید فراهم شود. این روشها مکمل روشهای کلاسیک هستند و در شرایطی که سرعت اهمیت دارد کاربردیاند.
✅ ویژگیهای اصلی این روش:
- سرعت بالا: نتایج سریعتر از روشهای سنتی ارائه میشوند
- کاهش زمان تصمیمگیری: امکان واکنش فوری به مشکلات احتمالی
- مناسب برای پایش سریع: ایدهآل برای خطوط تولید و کنترل مستمر
❌ با این حال، محدودیتهایی هم دارد:
- نیاز به تأیید با روش مرجع برای اطمینان از صحت نتایج
- هزینه بالاتر نسبت به روشهای کلاسیک
نکته حرفهای: روشهای سریع، زمانی که با روشهای استاندارد کلاسیک ترکیب شوند، تصویری سریع و قابل اعتماد از وضعیت میکروبی محصول ارائه میدهند و به تصمیمگیری علمی کمک میکنند.
مراحل انجام آزمایش میکروبی مواد غذایی
انجام آزمایش میکروبی مواد غذایی فقط به دستگاه یا آزمایشگاه محدود نمیشود. ترتیب و دقت در هر مرحله است که اعتبار و صحت نتایج را تعیین میکند.
۱. نمونهبرداری صحیح
همه چیز از اینجا شروع میشود. نمونهای که برداشت میکنید باید نماینده واقعی کل محصول باشد و هیچ آلودگی اضافی وارد آن نشود.
- نمونه باید به سرعت و در شرایط استریل منتقل شود
- کوچکترین خطا در این مرحله، کل آزمایش را بیاعتبار میکند
۲. آمادهسازی نمونه
این مرحله مثل آماده کردن بستر برای یک آزمایش دقیق است:
- نمونه همگن میشود تا تمام قسمتها به طور مساوی بررسی شوند
- رقتسازی استاندارد انجام میشود تا میکروبها قابل شمارش باشند
- محیط رشد کنترل شده است تا هیچ میکروب مفیدی نابود نشود و پاتوژنها قابل شناسایی باشند
۳. تلقیح و انکوباسیون
نمونهها وارد محیط کشت میشوند و برای رشد نیازمند شرایط کاملاً مشخص هستند:
- دما باید دقیق باشد
- زمان رشد استاندارد رعایت شود
- اتمسفر کنترل شده، یعنی میزان اکسیژن و CO₂ مناسب باشد
حتی کوچکترین انحراف میتواند نتیجه را کاملاً تغییر دهد، پس این مرحله حساسترین بخش آزمایش است.
۴. شمارش و تشخیص
وقتی میکروبها رشد کردند، مرحله اصلی شروع میشود:
- شمارش کلنیها برای سنجش سطح کلی آلودگی
- تشخیص پاتوژنها برای ارزیابی خطر واقعی سلامت
این مرحله فقط با دستگاه انجام نمیشود؛ تخصص و تجربه انسانی تعیینکننده است.
۵. گزارشدهی و تفسیر
اعداد خام فقط اعداد هستند؛ آنچه مهم است تفسیر علمی آنها و تبدیل دادهها به تصمیمهای عملی:
- ارائه گزارش دقیق و قابل فهم برای تولیدکننده و ناظر
- مشخص کردن اقدامات لازم برای حفظ کیفیت و ایمنی

خطاهای رایج در آزمایش میکروبی مواد غذایی
حتی در محیطهای حرفهای و آزمایشگاههای مجهز، خطاهای پرتکرار دیده میشوند. شناخت این خطاها به حفظ کیفیت و ایمنی محصول کمک میکند.
| خطای رایج | توضیح | پیامد |
|---|---|---|
| نمونهبرداری غیراستاندارد | انتخاب نمونه غیرنماینده یا انتقال نادرست | نتایج گمراهکننده و اعتبار آزمایش زیر سؤال میرود |
| عدم کنترل دما | رعایت نکردن دماهای استاندارد در نگهداری یا انکوباسیون | رشد میکروبها غیرطبیعی میشود و نتایج قابل اعتماد نیست |
| رقتسازی اشتباه | آمادهسازی رقتهای نادرست یا غیر دقیق | تعداد میکروبها به طور غیرواقعی بالا یا پایین نشان داده میشود |
| تفسیر نادرست دادهها | برداشت سطحی از اعداد و عدم توجه به استانداردها | تصمیمگیری اشتباه در مورد ایمنی محصول |
نکته حرفهای: حتی یک خطای کوچک در آزمایش میکروبی مواد غذایی میتواند امنیت غذایی مصرفکننده را به خطر بیندازد و نیازمند اصلاح فوری است.
ارتباط آزمایش میکروبی مواد غذایی با استانداردها و ایمنی
آزمایش میکروبی مواد غذایی بدون رعایت استانداردهای معتبر، مثل این است که بخواهیم مسیریابی کنیم اما نقشه نداشته باشیم. استانداردها مسیر را روشن میکنند: کدام میکروبها بررسی شوند، حد مجاز چقدر است و آزمایش چگونه اجرا شود. بدون این چارچوب، حتی بهترین آزمایش هم اعتبار علمی بینالمللی ندارد.
چرا محل آزمایش مهم است؟
حتی اگر تمام مراحل درست اجرا شود، انجام آزمایش در یک آزمایشگاه معتبر اهمیت زیادی دارد. یک آزمایشگاه مرجع:
- از روشهای بینالمللی استاندارد استفاده میکند
- تجهیزاتش کالیبره و تحت کنترل دقیق است
- نتایج را قابل ردیابی و بازبینی ارائه میدهد
اعتبار آزمایش، حاصل سیستم کنترل کیفیت است، نه صرفاً انجام یک تست.
نتایج آزمایش را نمیتوان برای همیشه معتبر دانست
نتایج آزمایش، عکس لحظهای از وضعیت محصول هستند. نمیتوان فرض کرد که یک آزمایش، همیشه صد درصد درست و قابل تعمیم باشد، چرا که:
- شرایط تولید ممکن است تغییر کند
- مواد اولیه همیشه ثابت نیستند
- عوامل محیطی در طول زمان نوسان دارند
بنابراین، آزمایش میکروبی مواد غذایی باید دورهای و بر اساس ریسک انجام شود، نه اینکه فقط یکبار اتفاق بیفتد.
آزمایش میکروبی؛ پل بین علم و سلامت
ایمنی غذایی یک مفهوم نظری نیست؛ یک زنجیره عملی است که سلامت واقعی مصرفکننده را تضمین میکند.
- آزمایش میکروبی مواد غذایی نقطه اتصال علم و سلامت است
- ابزاری است برای پیشگیری قبل از بروز مشکل
- اجازه میدهد تصمیمها براساس داده واقعی گرفته شوند
هر چه این حلقه ضعیفتر باشد، ریسک انسانی بالاتر میرود و احتمال بروز بحرانهای غذایی بیشتر میشود.
وقتی نتایج گمراهکننده میشوند
نتایج همیشه واقعیت مطلق نیستند. حتی عدد دقیق، اگر شرایط درست رعایت نشده باشد، میتواند مخاطب را گمراه کند:
- نمونه نماینده کل محصول نباشد
- استاندارد مرجع اشتباه انتخاب شود
- شرایط نگهداری رعایت نشود
در این حالت، عدد درست است، اما تفسیر نادرست میتواند تصمیمگیری را به خطا ببرد.
👈🏻 بدون این چارچوب، حتی بهترین آزمایش هم اعتبار علمی بینالمللی ندارد؛ جزئیات استانداردهای بینالمللی و نقش آزمایشگاه مرجع را میتوانید در مقاله آزمایشگاه مواد غذایی استانداردهای جهانی مطالعه کنید.
❓ سوالات متداول
1️⃣ آزمایش میکروبی مواد غذایی چیست و چرا انجام میشود؟
آزمایش میکروبی مواد غذایی فرایندی است که در آن نمونه غذایی برای شناسایی، تعیین نوع و میزان میکروارگانیسمها بررسی میشود تا ایمنی و سالمبودن غذا قبل از مصرف تأیید گردد.
2️⃣ چه استانداردهایی برای آزمایش میکروبی مواد غذایی باید رعایت شود؟
نتایج آزمایش باید با استانداردهای بینالمللی مانند مقررات میکروبیولوژیکال کریتریا و استانداردهای معتبر آزمایشگاهی مطابقت داشته باشد تا مشخص شود چه میزان میکروب در غذا قابل قبول است و چه میزان خطرناک است.
3️⃣ هر چند وقت یکبار باید آزمایش میکروبی انجام شود؟
بسته به نوع ماده غذایی، ریسک آلودگی میکروبی و قوانین بازار هدف، این آزمایشها به صورت دورهای، طبق ارزیابی ریسک و بر اساس استانداردهای بهداشتی تکرار میشوند، نه فقط یک بار برای همیشه.
4️⃣ اگر نتیجه آزمایش میکروبی غیرقابل قبول باشد، چه باید کرد؟
نتایج غیرقابل قبول معمولاً نشاندهنده نقص در فرآیند تولید، آلودگی متقاطع یا شرایط نگهداری نامناسب هستند و باید اقدامات اصلاحی فوری برای حفظ ایمنی و کیفیت غذا انجام گردد.
5️⃣ نتیجه منفی در آزمایش میکروبی به چه معناست؟
نتیجه منفی به این معناست که در نمونه و زمان انجام آزمایش هیچ میکروب خطرناکی یافت نشده است، اما این به معنی تضمین سلامت کامل در همه شرایط نیست؛ نتایج باید همراه با استانداردها و دادههای دورهای تفسیر شوند.
نتیجهگیری؛ وقتی عددها حرف میزنند
آزمایش میکروبی مواد غذایی چیزی فراتر از یک الزام فنی است. این عددها، زبان خاموش کیفیت و ایمنی محصول هستند؛ زبانی که اگر درست شنیده و تفسیر شود، میتواند از بحرانهای بزرگ انسانی جلوگیری کند.
اما سؤال واقعی این است:
آیا شما آمادهاید این عددها را بشنوید و بر اساس آنها تصمیم بگیرید، یا صرفاً به آنها نگاه میکنید و از کنارشان میگذرید؟
دانستن اینکه چه زمانی، چرا و چگونه به این نتایج اعتماد کنیم، مرز میان تولید مسئولانه و ریسک پنهان است. هر عدد یک داستان دارد، و تنها کسی که با دقت گوش کند، میتواند آن داستان را بخواند.
حالا نوبت شماست: کدام بخش از آزمایش میکروبی مواد غذایی برایتان مبهم است؟ چه تجربهای داشتهاید؟ کامنت خود را با ما به اشتراک بگذارید و با هم این زبان خاموش را کشف کنیم.
منابع:




